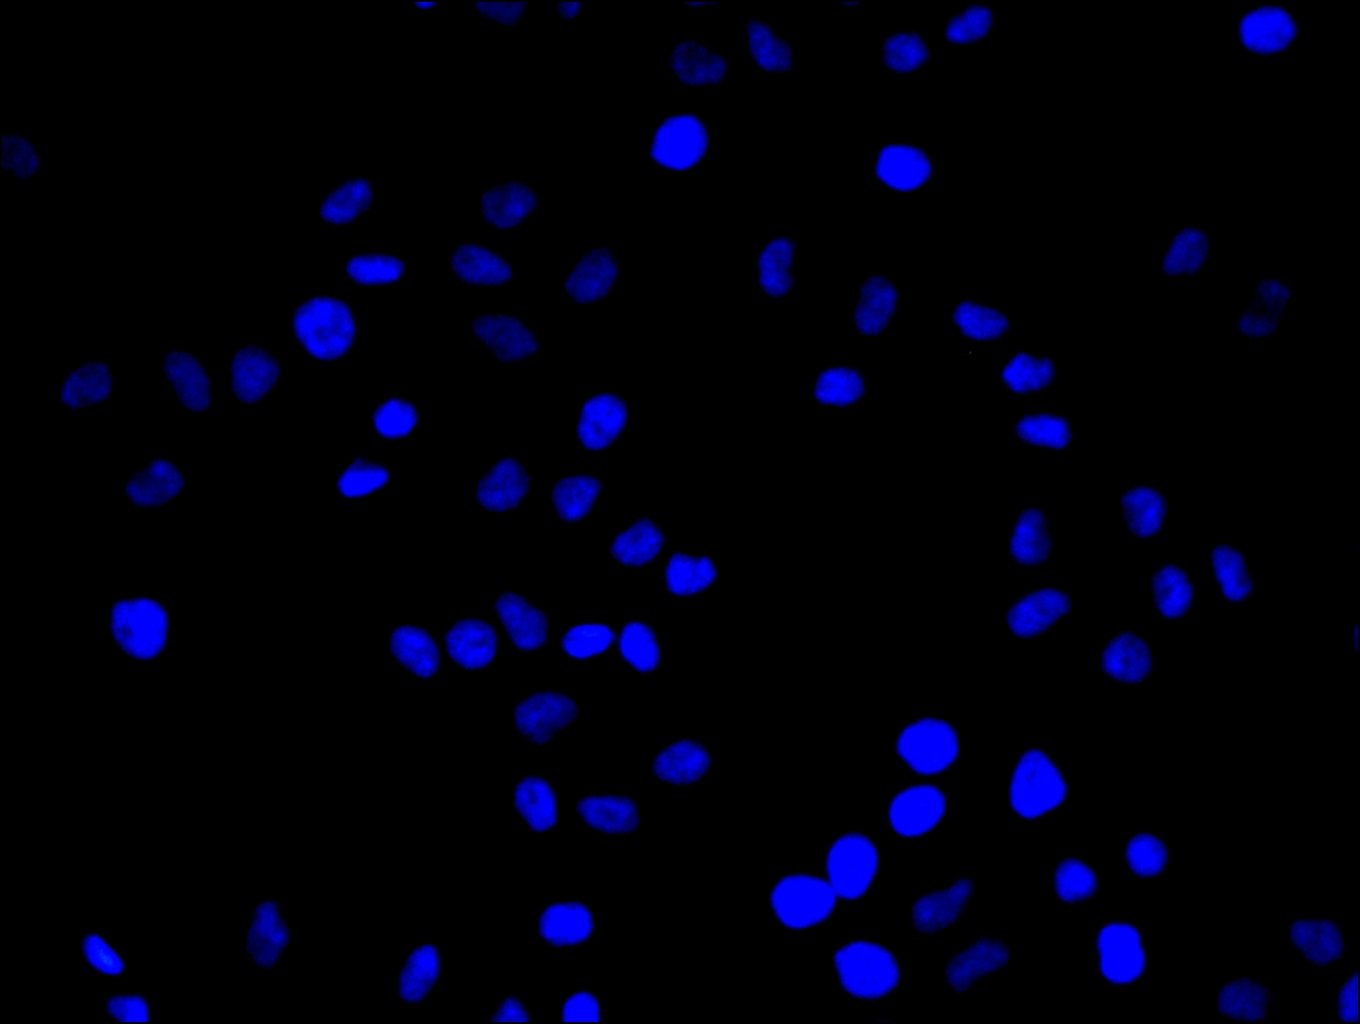

ID1, or Inhibitor of DNA Binding 1, functions as a dominant-negative regulator of basic helix-loop-helix transcription factors, playing a critical role in controlling cellular differentiation and proliferation. By preventing DNA binding of transcription factor complexes, ID1 helps maintain cells in a proliferative, undifferentiated state—a mechanism that has drawn significant attention in cancer research, where ID1 overexpression is frequently associated with tumor progression, metastasis, and poor prognosis across multiple malignancies.
This recombinant monoclonal antibody (clone 2C7) offers the reproducibility essential for longitudinal studies and multi-site collaborations. Generated against a synthetic peptide derived from human ID1, the sequence-defined nature of recombinant production ensures consistent epitope recognition across lots, eliminating the variability that can compromise experimental comparisons over time.
Validation data demonstrates robust performance across multiple applications. In western blotting, the antibody reliably detects ID1 in a diverse panel of human cell lines including 293T, HepG2, 293, A549, U251, A431, BxPC-3, and HeLa, as well as mouse brain tissue, confirming cross-species reactivity for human and mouse samples. The observed band at 22 kDa runs slightly higher than the predicted 17 kDa molecular weight, which likely reflects post-translational modifications such as phosphorylation that are known to regulate ID1 stability and function. Immunofluorescence applications have been validated in PC-3 and HeLa cells, enabling subcellular localization studies of this nuclear protein.
Whether investigating ID1's role in stem cell maintenance, epithelial-mesenchymal transition, or therapeutic resistance mechanisms, this antibody provides a dependable tool for epigenetics, signal transduction, and cancer biology research programs.